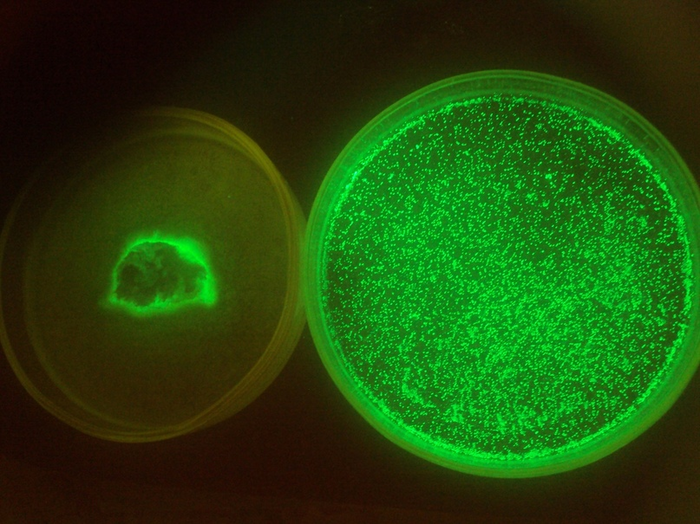

Доброго времени товарищи! Сегодня НПО ДУСТХИМХАБРПРОМ хочет продемонстрировать вам гамма-спектры некоторых «экзотических» радиоактивных изотопов.
Гамма-спектрометры применяются для определения содержания радионуклидов в теплоносителе, в воздухе помещений, в жидких сбросах, при контроле объектов внешней среды, при контроле внутреннего облучения персонала и во многих других случаях с целью контроля или расследования причин загрязнений радиоактивными веществами.
Любая форма контроля физических параметров в конечном счете сводится к измерению каких-либо величин. Для работников, имеющих дело, с ионизирующими излучениями, наиболее интересны следующие из них: поглощенная, экспозиционная и эквивалентная дозы и их мощность, плотность потока частиц, флюенс частиц, объемная, массовая, поверхностная, эффективная активности.
Задача контроля активности в каком-либо объекте (теплоносителе, сбросной воде, воздухе и т.п.) по естественным и искусственным радионуклидам состоит в регистрации гамма-квантов, образующихся в измеряемом образце при ядерных превращениях ядер радиоактивных нуклидов, содержащихся в нем. Умножая количество зарегистрированных гамма-квантов на определенные коэффициенты, получим активность радиоактивных нуклидов в образце.
Необходимо только учесть, что коэффициенты различны для разных нуклидов и различных детекторов, поэтому нужно не просто зафиксировать гамма-кванты, вылетающие из образца, но и точно знать, ядра каких нуклидов их испускают. Известно, что каждый радиоактивный нуклид испускает гамма-кванты нескольких вполне определенных энергий (говорят, что имеет несколько линий). По совокупности линий можно однозначно определить, какой именно нуклид содержится в пробе.
Таким образом, измерение активности нуклидов в образце состоит из двух частей: определения нуклида и определения его активности.
Задача определения энергий гамма-квантов и идентификации нуклида более или менее успешно решается четырьмя типами детекторов: ионизационными камерами, пропорциональными счетчиками, полупроводниковыми и сцинцилляционными детекторами.
Вашему вниманию представляются некоторые спектрограммы радионуклидов.
ИЗОТОП: ТИТАН — 44, период полураспада около 60 лет
ИЗОТОП: ЕВРОПИЙ — 152, период полураспада около 13,5 лет
ИЗОТОП: НАТРИЙ — 22, период полураспада около 2,6 лет
ИЗОТОП: КАДМИЙ — 109, период полураспада около 461,4 суток
ИЗОТОП: ВОДОРОД — 3 (тритий), период полураспада около 12,32 лет
РАДИОХИМИЧЕСКИЕ ОПЫТЫ
От нечего делать решил немного порадиохимичить. Был у меня остаток от выщелачивания сернокислого, довольно активный и дающий спектр радия. Так вот решил я его обработать карбонатным раствором и посмотреть что из этого получится. В общем грел и крутил на мешалке. Потом профильтровал, получил прозрачный светло-желтый раствор. Спектр сначала был вроде как более менее стандартный радиевый, но активность дочек постепенно падает, а пик свинца-210 соответственно относительно них увеличивается. Следовательно, в раствор перешло некоторое количество дпр и немного радия так как скорость распада дпр выше чем скорость образования.
Следите за новостями радиохимии вместе с НПО ДУСТХИМХАБРПРОМ